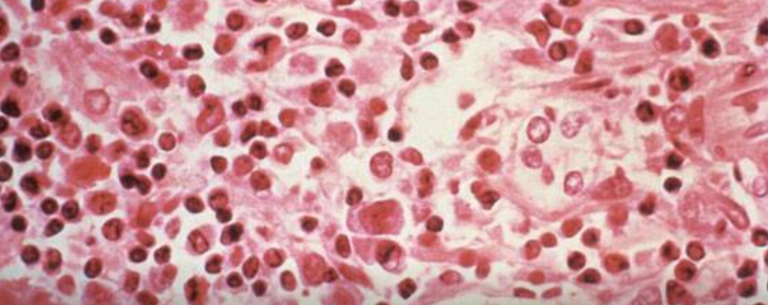

एजेन्सी ।
चीनको वुहानबाट सुरु भएको कोरोना भाइरसले विश्व महामारीको रुप ल्याएको छ। चीनपछि १९५ देशमा कोरोना भाइरसको महामारी फैलिएको छ। कोरोना भाइरसको महामारीको युद्धपछि चीनमा फेरि अर्को भाइरस देखा परेको छ।
उक्त भाइरसले चीनको युनान प्रोविन्समा एक व्यक्तिको ज्यान लिएको चिनियाँ अधिकारीलाई उदृत गर्दै अन्तर्राष्ट्रिय सञ्चारमाध्यमले जनाएका छन। हंता नामको उक्त भाइरसबाट ज्यान गुमाएका ती व्यक्ति एक बसमा यात्रा गरिरहेका थिए।
ती व्यक्तिको हंता नामको भाइरसबाट ज्यान गएपछि बसमा सवार अन्य ३२ यात्रुको स्वास्थ्य जाँच गरेर निगरानीमा राखिएको समाचारमा जनाइएको छ। के हो हंता भाइरस ? हंता भाइरस कुनै एक मात्र भाइरस हैन्। यो कयौँ भाइरसको समुह हो। जसलाई हंता नामबाट संवोधन गरिन्छ।
यो भाइरस विशेषगरी मुसामा पाइन्छ। तर यो भाइरसले मुसालाई भने केही असर गर्दैन्। हंता भाइरस कुनै नयाँ भाइरस भने होइन्। यो विश्वका विभिन्न शहरमा पहिलेदेखि नै देखिएको थियो। यो भाइरस एसिया, अफ्रीकादेखि लिएर अमेरिकासम्मका देशमा भेटिएको छ।
हंता भाइरसबाट मानिसलाई कयौँ प्रकारका समस्या देखिने गर्दछन्। हंता भाइरसबाट हुने विरामीमा हल्का ज्वरो वा फ्लूदेखि लिएर श्वासप्रश्वासको गम्भिर समस्या देखिन्छ। यसबाट रक्तसञ्चार र मृगौलामा समेत असर पार्ने वैज्ञानिकले बताएका छन्।

प्रतिक्रिया